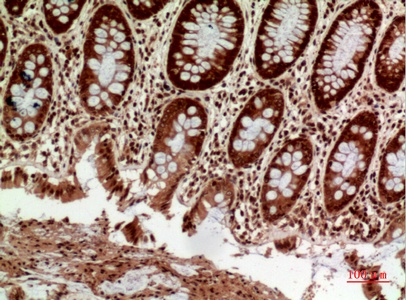
Fig.2. Immunohistochemical analysis of paraffin-embedded human-colon, antibody was diluted at 1:100.
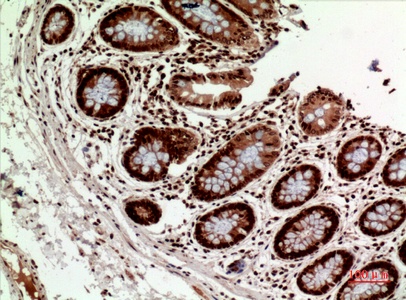
Fig.3. Immunohistochemical analysis of paraffin-embedded human-colon, antibody was diluted at 1:100.

| Product name | HLA-DQB1/2 Polyclonal Antibody |
| Immunogen | Synthesized peptide derived from the Internal region of human HLA-DQB1/2 |
| Host | Rabbit |
| Reactivity | Human |
| Applications | WB,IHC,IF,ELISA |
| Applications notes | Optimal working dilutions should be determined experimentally by the investigator. Suggested starting dilutions are as follows: WB 1:500-1:2000;IHC: 1:100-1:300;ELISA 1:20000;IF 1:50-200 |
| Clonality | Polyclonal |
| Preparation method | The antibody was affinity-purified from rabbit antiserum by affinity-chromatography using epitope-specific immunogen. |
| Alternative | HLA-DQB1; HLA-DQB; HLA class II histocompatibility antigen, DQ beta 1 chain; MHC class II antigen DQB1; HLA-DQB2; HLA-DXB; HLA class II histocompatibility antigen, DQ beta 2 chainHLA class II histocompatibility antigen, DX beta chain; MHC class II antigen DQB2 |
| Formulation | Liquid solution |
| Concentration | 1 mg/ml |
| Molecular weight | 30kD |
| Storage buffer | Liquid in PBS containing 50% glycerol, 0.5% BSA and 0.02% sodium azide. |
| Storage instructions | Stable for one year at -20°C from date of shipment. For maximum recovery of product, centrifuge the original vial after thawing and prior to removing the cap. Aliquot to avoid repeated freezing and thawing. |
| Shipping | Gel pack with blue ice. |
| Precautions | The product listed herein is for research use only and is not intended for use in human or clinical diagnosis. Suggested applications of our products are not recommendations to use our products in violation of any patent or as a license. We cannot be responsible for patent infringements or other violations that may occur with the use of this product. |
| Background | HLA-DQB1 belongs to the HLA class II beta chain paralogs. This class II molecule is a heterodimer consisting of an alpha (DQA) and a beta chain (DQB), both anchored in the membrane. It plays a central role in the immune system by presenting peptides derived from extracellular proteins. Class II molecules are expressed in antigen presenting cells (APC: b lymphocytes, dendritic cells, macrophages). The beta chain is approximately 26-28 kDa and it contains six exons. Exon 1 encodes the leader peptide, exons 2 and 3 encode the two extracellular domains, exon 4 encodes the transmembrane domain and exon 5 encodes the cytoplasmic tail. Within the DQ molecule both the alpha chain and the beta chain contain the polymorphisms specifying the peptide binding specificities, resulting in up to four different molecules. Typing for these polymorphisms is routinely done for bone marrow transplantation. Alternative splicing results in multiple transcript variants. [provided by RefSeq, Sep 2011]HLA-DQB1 (Major Histocompatibility Complex, Class II, DQ Beta 1) is a Protein Coding gene. Diseases associated with HLA-DQB1 include celiac disease and multiple sclerosis, disease progression, modifier of. Among its related pathways are Immune System and Interferon gamma signaling. Gene Ontology (GO) annotations related to this gene include peptide antigen binding and MHC class II receptor activity. An important paralog of this gene is HLA-DMA. Binds peptides derived from antigens that access the endocytic route of antigen presenting cells (APC) and presents them on the cell surface for recognition by the CD4 T-cells. The peptide binding cleft accommodates peptides of 10-30 residues. The peptides presented by MHC class II molecules are generated mostly by degradation of proteins that access the endocytic route, where they are processed by lysosomal proteases and other hydrolases. Exogenous antigens that have been endocytosed by the APC are thus readily available for presentation via MHC II molecules, and for this reason this antigen presentation pathway is usually referred to as exogenous. As membrane proteins on their way to degradation in lysosomes as part of their normal turn-over are also contained in the endosomal/lysosomal compartments, exogenous antigens must compete with those derived from endogenous components. Autophagy is also a source of endogenous peptides, autophagosomes constitutively fuse with MHC class II loading compartments. In addition to APCs, other cells of the gastrointestinal tract, such as epithelial cells, express MHC class II molecules and CD74 and act as APCs, which is an unusual trait of the GI tract. To produce a MHC class II molecule that presents an antigen, three MHC class II molecules (heterodimers of an alpha and a beta chain) associate with a CD74 trimer in the ER to form a heterononamer. Soon after the entry of this complex into the endosomal/lysosomal system where antigen processing occurs, CD74 undergoes a sequential degradation by various proteases, including CTSS and CTSL, leaving a small fragment termed CLIP (class-II-associated invariant chain peptide). The removal of CLIP is facilitated by HLA-DM via direct binding to the alpha-beta-CLIP complex so that CLIP is released. HLA-DM stabilizes MHC class II molecules until primary high affinity antigenic peptides are bound. The MHC II molecule bound to a peptide is then transported to the cell membrane surface. In B-cells, the interaction between HLA-DM and MHC class II molecules is regulated by HLA-DO. Primary dendritic cells (DCs) also to express HLA-DO. Lysosomal microenvironment has been implicated in the regulation of antigen loading into MHC II molecules, increased acidification produces increased proteolysis and efficient peptide loading. |
| Gene ID | 100507714 |
| Alternative | HLA-DQB1; HLA-DQB; HLA class II histocompatibility antigen, DQ beta 1 chain; MHC class II antigen DQB1; HLA-DQB2; HLA-DXB; HLA class II histocompatibility antigen, DQ beta 2 chainHLA class II histocompatibility antigen, DX beta chain; MHC class II antigen DQB2 |
| Others | HLA-DQB1/2 Polyclonal Antibody detects endogenous levels of HLA-DQB1/2 protein. |
| Accession | P01920/P05538 |
| Observed Band(KD) | 30 |

Fig.1. Western Blot analysis of PC12 cells using HLA-DQB1/2 Polyclonal Antibody. Secondary antibody (catalog#: A21020) was diluted at 1:20000.
Fig.2. Immunohistochemical analysis of paraffin-embedded human-colon, antibody was diluted at 1:100.
Fig.3. Immunohistochemical analysis of paraffin-embedded human-colon, antibody was diluted at 1:100.

Fig.4. Immunohistochemical analysis of paraffin-embedded human-spleen, antibody was diluted at 1:100.
You must be logged in to post a review.
Reviews
There are no reviews yet.